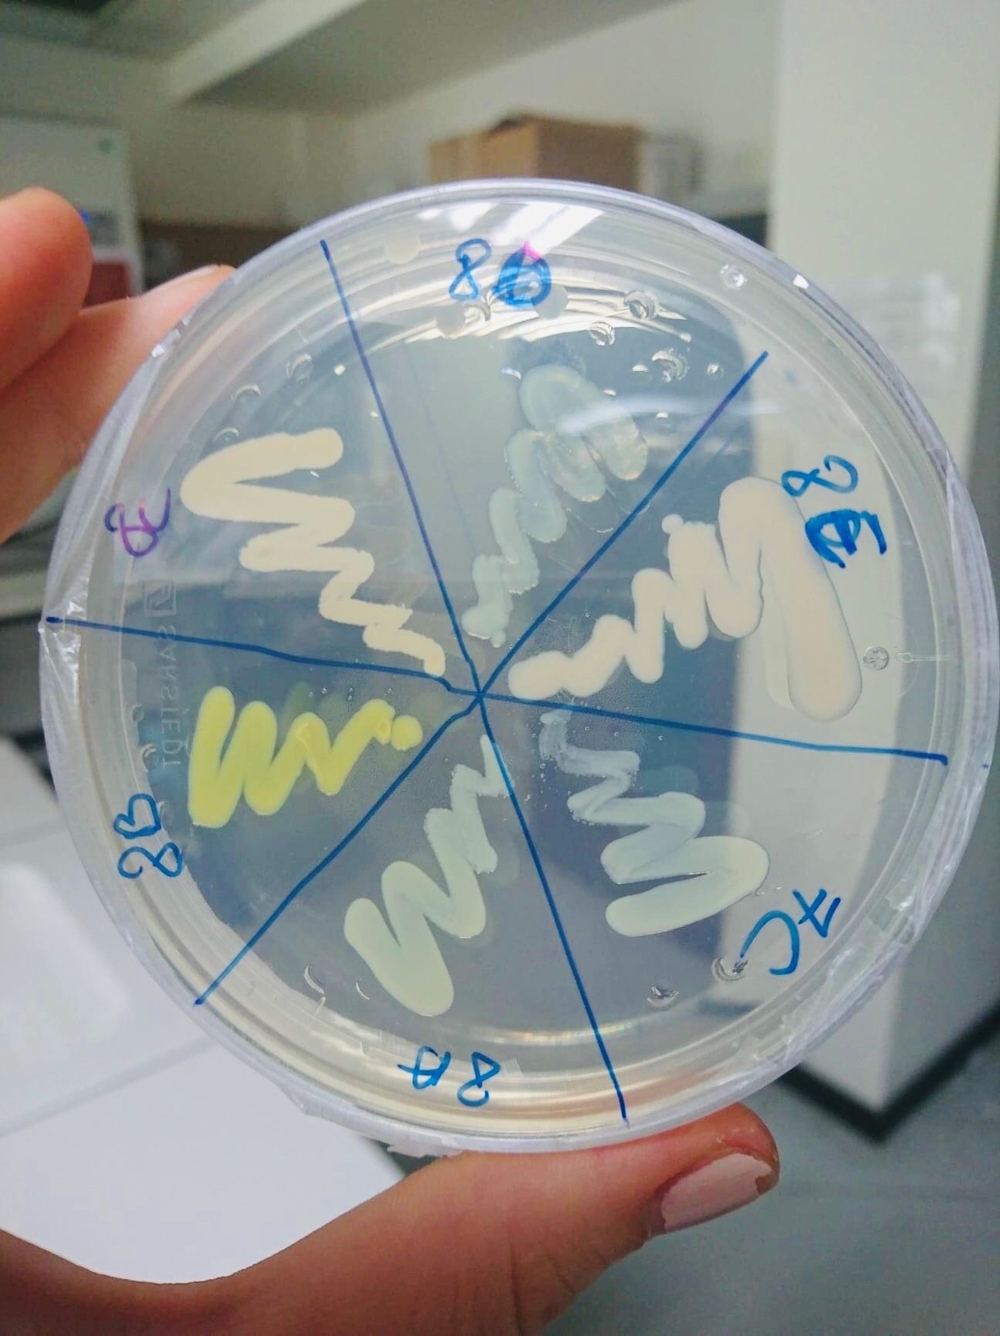

Więcej o projekcie prowadzonym przez dr hab. Magdalenę Urbaniak, prof. UŁ oraz mgr Elżbietę Mierzejewską o roślinach dyniowatych biorących udział w procesie oczyszczania gleby pisaliśmy niedawno TUTAJ.
O pracach prowadzonych przez laureatkę z Uniwersytetu Łódzkiego informuje również redakcja Rzeczy o Innowacjach.
"Chcemy usuwać zanieczyszczenia z gleby, a po drugie chcemy znaleźć naturalny i zrównoważony sposób w jaki będziemy się pozbywać tych zanieczyszczeń. Dodatkowo chcemy też (…) filtrować środowisko, zapobiegać rozprzestrzenianiu się herbicydów na szeroką skalę."
mgr Elżbieta Mierzejewska wyjaśnia cel swoich badań.
Posłuchajmy rozmowy z mgr Elżbietą Mierzejewską nagranej przez Forum Inteligentnego Rozwoju:
Kontynuacja badań w Belgii
Nasza doktorantka już od miesiąca przebywa na stażu naukowym w Centrum Badań Środowiskowych (CMK) na Uniwersytecie w Hasselt (Belgia), gdzie ma możliwość kontynuacji swoich badań. W trakcie stażu, finansowanego przez Narodowe Centrum Nauki w ramach projektu ETUIDA 7 prowadzi badania nad interakcjami pomiędzy środowiskiem glebowym, mikroorganizmam glebowymi, roślinami i fitozwiązkami. Szczególną uwagę poświęca bakteriom endofitycznym- tj. bakteriom zasiedlającym wnętrze tkanek roślinnych. Są one tym bardziej interesujące, gdyż mogą być wykorzystywane jako efektywne narzędzie do zmniejszenia stężenia herbicydów z grupy fenoksykwasów w glebie oraz promowania wzrostu rośliny na zanieczyszczonym terenie. CMK w Hasselt specjalizuje się w badaniach nad endofitami, dlatego jest duża szansa, że staż naukowy zakończy się powodzeniem.
Izolacja endofitów (bakterii) w CMK (Belgia); zdjęcie źródło prywatne

Pozyskiwanie gleby ze strefy korzeniowej (gleba ryzosferowa) w CMK (Belgia); zdjęcie źródło prywatne
Materiał źródłowy: Forum Inteligentnego Rozwoju, Koło Naukowe Ekohydrologii UŁ
Redakcja: Centrum Promocji UŁ

